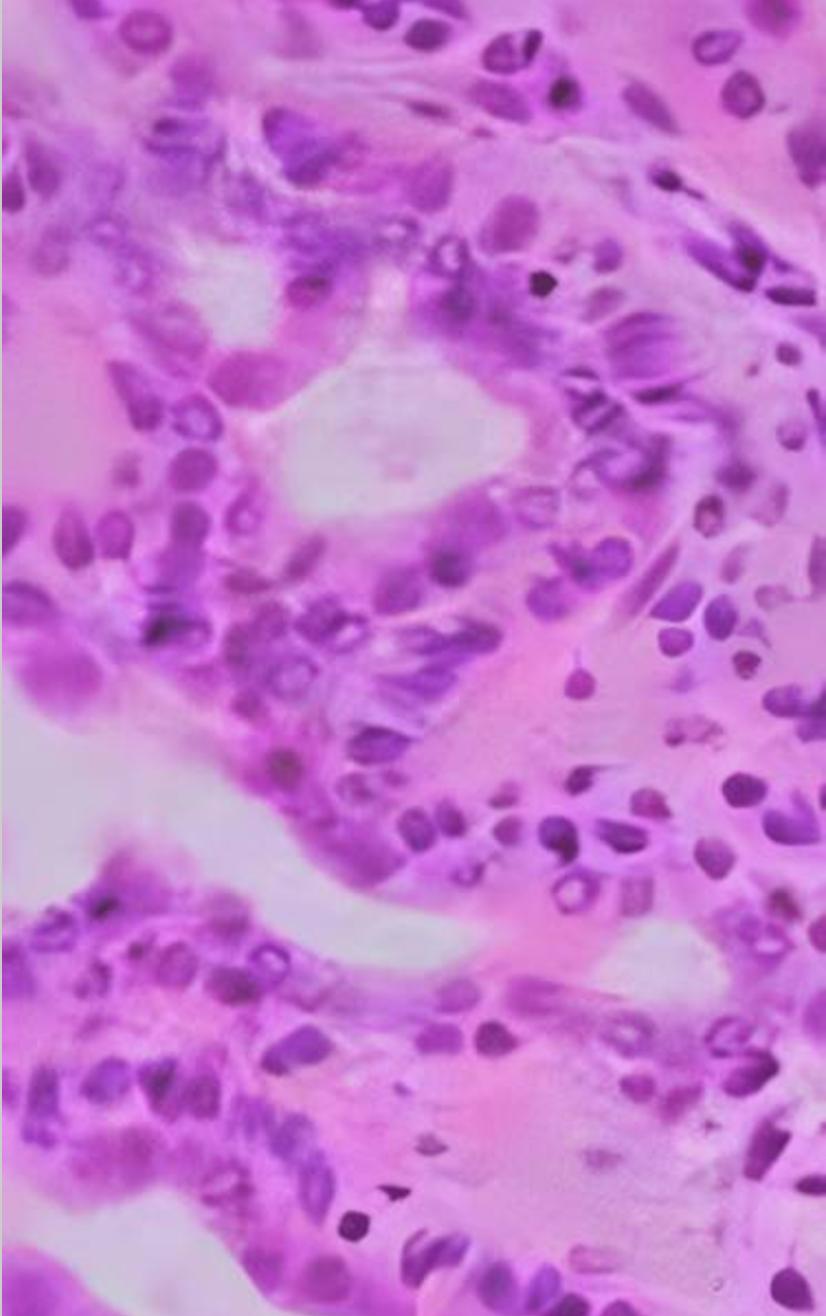

鼻腔多形性腺瘤
来源:医博士 | 2024-11-29
多形性腺瘤(PA)是最常见的良性涎腺肿瘤,通常发展缓慢且无症状,通常发生在30-60岁的女性。导致PA的病因尚未知,目前一些研究表明,致癌的SV40和EBV病毒以及包括PLAG1和HMGA2在内的遗传因素可能在发病或进展中发挥作用。在显微镜下观,PA表现为多边形上皮细胞和纺锤形肌上皮细胞在粘液、粘液、软骨或透明物质等不同基质中的组合。上皮细胞通常被与相邻基质融合的肌上皮层包围。肿瘤没有真正的包膜,而是被厚度不同的纤维假性包膜包裹。
PA诊断通常依赖于细针穿刺(FNA)、超声(USG)和计算机断层扫描(CT)。PA占唾液腺所有肿瘤的66%,在85%的病例中累及腮腺浅叶。在极少数情况下也可能发生在腮腺以外的鼻腔等部位。PA在鼻腔中的发病率仅为0.4%,由于其罕见性和鼻腔的复杂解剖结构,存在诊断和手术挑战。识别非典型部位的PA对于及时干预和管理以预防复发或恶化等并发症至关重要。此类病例的鉴别诊断包括腺癌、粘液表皮样癌和嗅神经母细胞瘤等其他良性和恶性肿瘤,需要仔细的组织病理学评估,以确保准确诊断和适当治疗。
病例介绍
一位87岁的女性患者因左侧鼻漏、鼻后滴和反酸就诊。患者的生命体征稳定,心率76 bpm,血压为126/70mmHg。既往病史包括高胆固醇、高血压、青光眼、神经病变、焦虑和心动过速。否认鼻腔或唾液腺肿瘤家族史,对氟替卡松喷鼻剂过敏。
患者主诉左鼻孔出现鼻部不适,鼻腔通畅性降低,给药后(0.03%异丙托溴铵和生理盐水喷雾)从左鼻孔流出。鼻镜和CT扫描显示,左鼻孔内鼻前庭顶部有一个8x8毫米的肉质肿块(图1)。

图1 轴位CT扫描显示左鼻腔8x8mm肿物
考虑到患者的年龄、整体健康状况和肿块的位置,选择全身麻醉下切除肿物,病理学检查提示肿物为PA(图2)。术后患者诉其鼻部症状明显改善,不适减轻且鼻腔通畅性改善。考虑到PA复发或并发症的可能性,每三个月随访以监测复发情况。
图2 PA的组织学表现
讨论
鼻内PA的鉴别诊断包括各种良性和恶性肿瘤,如鳞状细胞癌、腺癌、腺样囊性癌、粘液表皮样癌、黑色素瘤、嗅神经母细胞瘤、息肉、乳头状瘤(包括内翻性乳头状瘤)、血管纤维瘤和骨瘤。
手术切除是治疗PA的主要方法,大约2.4%的鼻腔PA有可能癌变,建议完全切除以防止恶化。PA术后复发率约为7.5%,安全缘、包膜破裂和肿瘤溢出是导致复发的主要因素。
所采用的手术方法取决于肿瘤的大小、位置和范围,可能包括鼻侧切开术、经鼻或面部脱套术或鼻内切除术。当手术切缘呈阳性时,术后放射治疗(RT)被认为可以改善局部控制。
然而,术后放疗存在争议,因此只考虑在反复复发的情况下使用。恢复的速度、患者的年龄以及第一次手术切除的效果等因素影响RT的选择。PA恶化的机制缺乏全面了解,但MUC1、HMGIC扩增和MDM2过表达等标志物可能提示复发的风险。
医博士编译自:Basharat R, Bjorling A & Samara G. Pleomorphic Adenoma of the Nasal Cavity. Cureus. 2024; 16(8):e65969. doi:10.7759/cureus.65969
声明: 所有注明“来源:医博士”的文字、图片和音视频资料,版权均属于医博士所有,转载须注明“来源:医博士”;所有转载文章系出于传递更多信息之目的,且明确注明来源和作者,不希望被转载的媒体或个人可与我们联系,我们将立即进行删除处理。